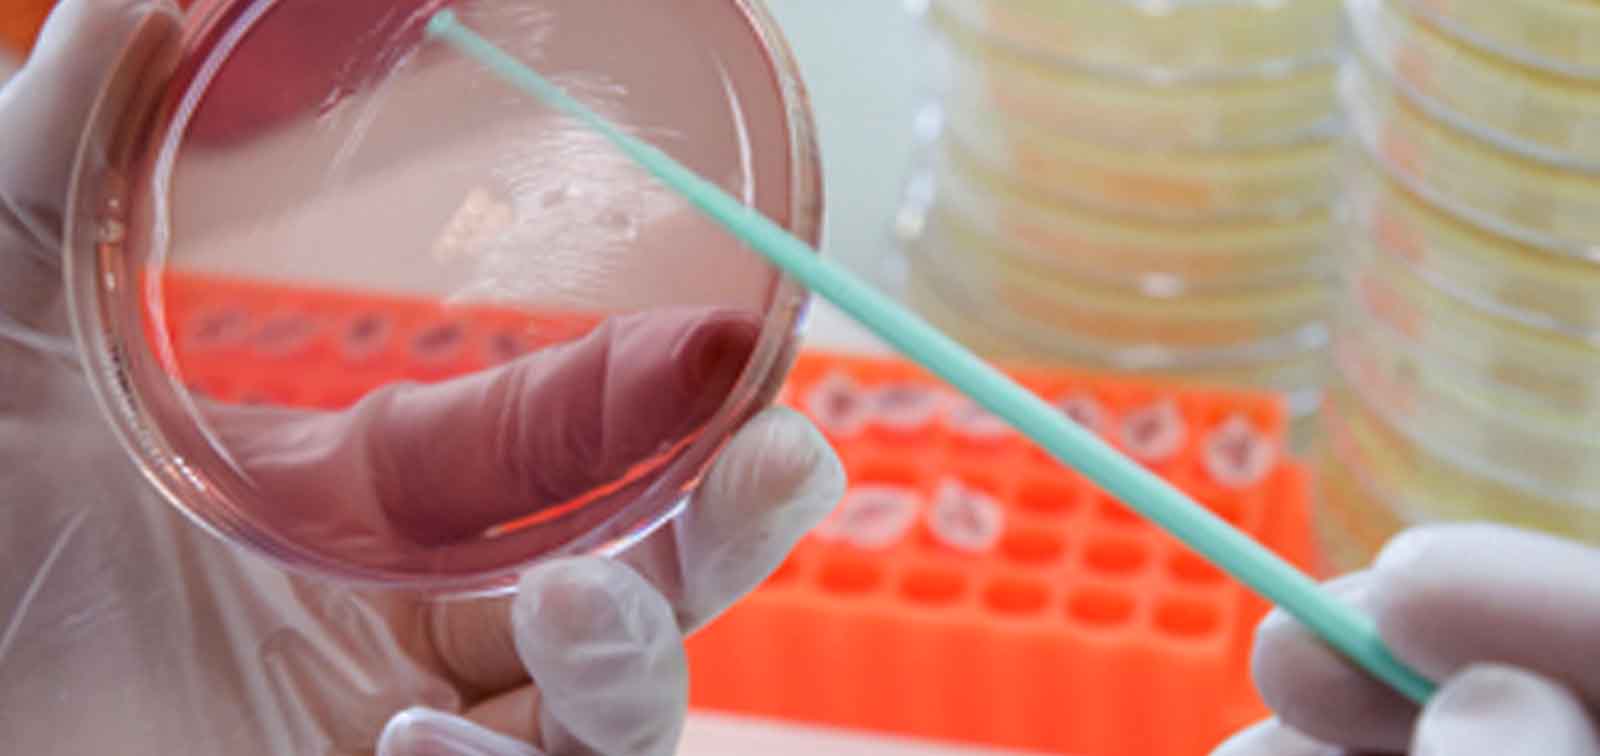

Chagas
Volem sumar-nos als esforços internacionals dirigits a prevenir, tractar i controlar la malaltia de Chagas.
Et mantindrem al dia de les nostres activitats i estudis científics.
Les nostres Iniciatives busquen potenciar l'impacte del nostre treball més enllà de l'esfera científica. Parteixen d'àrees en les quals tenim un lideratge científic internacional i exploren tots els elements possibles de translació per aportar solucions als principals reptes actuals en salut global

Volem sumar-nos als esforços internacionals dirigits a prevenir, tractar i controlar la malaltia de Chagas.

La nostra feina se centra en reforçar les estratègies de lluita contra la malària i en avançar en l'eliminació de la malaltia.

Treballem per promoure ciutats sostenibles i saludables a partir de l'evidència científica.
Contribuïm al coneixement de les causes i factors de risc de les resistències antimicrobianes i al desenvolupament de nous medicaments i vacunes.

Treballem per accelerar el progrés en la salut de les dones i els nens i nenes, i per avançar en l'Agenda de Desenvolupament Sostenible.
Al web d'ISGlobal no trobaràs publicitat ni cookies per fer un seguiment personalitzat. Només fem servir cookies, pròpies i de tercers, per millorar la teva experiència de navegació, protegir la teva privadesa, saber quantes persones ens visiten i quins continguts susciten més interès, com les cookies analítiques de Google. Pots "Acceptar totes les cookies", "Rebutjar cookies opcionals" (excepte les cookies tècniques que són necessàries) i "Configurar cookies". Per a més detalls, pots consultar la nostra política de cookies i la nostra política de privadesa.

El nostre lloc web www.isglobal.org (el “Lloc Web”) utilitza una tecnologia denominada “cookies” amb la finalitat de poder recollir informació sobre l’ús del Lloc Web.
Una cookie és un arxiu que es descarrega al seu equip (ordinador o dispositiu mòbil) amb la finalitat d’emmagatzemar dades que podran ser actualitzades i recuperades per l’entitat responsable de la seva instal·lació.
La informació aconseguida a través de les cookies pot incloure la data i l’hora de visites al Lloc Web, les pàgines vistes, el temps que ha passat al nostre Lloc Web i els llocs visitats just abans i just després d’aquest.
L’informem que podem utilitzar cookies amb la finalitat de facilitar la seva navegació pel Lloc Web, proporcionar-li una millor experiència en navegar-hi, distingir-lo d’altres usuaris, i identificar problemes amb la finalitat de millorar el Lloc Web. Així mateix, en cas que vostè atorgui el seu consentiment, utilitzarem cookies que ens permetin obtenir més informació sobre les seves preferències i personalitzar el Lloc Web, d’acord amb els seus interessos individuals.
La present política de cookies té la finalitat d’informar-lo de manera clara i precisa sobre les cookies que s’utilitzen al nostre Lloc Web (la “Política de Cookies”). En cas que vulgui obtenir més informació sobre les cookies que utilitzem al Lloc Web, podrà enviar un correu electrònic a l’adreça següent: lopd@isglobal.org.
El nostre lloc web utiliza les cookies que es descriuen tot seguit:
Són les cookies que s’envien al seu ordinador i es gestionen exclusivament per nosaltres amb la finalitat d’assolir un millor funcionament del Lloc Web. La informació que recollim es fa servir per millorar la qualitat del nostre servei i la seva experiència com a usuari. Aquestes cookies romanen al seu navegador més temps, i ens permeten reconèixer-lo com a visitant periòdic del Lloc Web i adaptar-ne el contingut per poder oferir-li continguts que s’ajustin a les seves preferències.
Si interactua amb el contingut del nostre Lloc Web, també poden establir-se cookies de tercers (per exemple, en prémer botons de xarxes socials o reproduir vídeos allotjats en un altre lloc web). Les cookies de tercers són les establertes per un domini diferent del nostre Lloc Web. No podem accedir a les dades emmagatzemades a les cookies d’altres llocs web quan navegui als llocs web en qüestió.
Al nostre Lloc Web utilitzem el sistema de mesura d’audiència Google Analytics, Facebook, First Party, Twitter, Vimeo, Youtube, Instagram, Issuu y Opinion Stage. Aquestes eines ens permeten conèixer com interactuen els usuaris del nostre Lloc Web. Les cookies emprades es consideren “persistents”, és a dir que les dades continuen emmagatzemades al terminal i, per tant, el responsable de la cookie pot accedir-hi i pot tractar-les durant un període definit que pot anar d’uns minuts a diversos anys.
Tot seguit, classifiquem les cookies segons la finalitat per la qual es tractin les dades obtingudes:
Aquestes cookies, juntament amb els nostres arxius de registre del servidor, ens permeten conèixer el nombre total d’usuaris que visiten el Lloc Web i les parts del Lloc Web que gaudeixen d’una major popularitat. Gràcies a aquestes cookies obtenim una informació que pot ajudar-nos a millorar la navegació i brindar un millor servei a usuaris i clients.
Facilitem, tot seguit, un enllaç al lloc web de Google on pot consultar la descripció del tipus de cookies que utilitza Google Analytics i el seu període d’expiració.
En navegar i continuar al nostre Lloc Web estarà consentint l’ús de les cookies abans mencionades, pels terminis indicats i en les condicions contingudes en aquesta Política de Cookies.
Com que les cookies no són necessàries per a l’ús del nostre Lloc Web, l’informem que pot bloquejar-les o deshabilitar-les a través de la configuració del seu navegador que li permet rebutjar la instal·lació de totes les cookies o d’algunes. La majoria de navegadors permeten advertir la presència de cookies o rebutjar-les automàticament. Si les rebutja podrà seguir usant el nostre Lloc Web, encara que l’ús d’alguns dels seus serveis pot ser limitat i, per tant, la seva experiència al nostre Lloc Web pot resultar menys satisfactòria.
Si, en qualsevol moment, volgués revocar el seu consentiment relacionat amb aquesta Política de Cookies, haurà d’eliminar les cookies emmagatzemades al seu equip (ordinador o dispositiu mòbil) a través dels ajustos i configuracions del navegador d’Internet. Per a més informació sobre l’eliminació, deshabilitació o bloqueig de les cookies, li recomanem que visiti aquesta pàgina.
Tret que hagi ajustat la configuració del seu navegador, el nostre sistema crearà cookies així que visiti el nostre Lloc Web. Tingui present que tots els navegadors d’Internet permeten el canvi d’aquesta configuració. Per a més informació sobre la manera d’ajustar les configuracions de cookies als següents navegadors, el remetem a l’enllaç pertinent:
És possible que actualitzem la Política de Cookies del nostre Lloc Web. Per això, recomanem que revisi aquesta política cada cop que accedeixi al nostre Lloc Web amb la finalitat d’estar adequadament informat/da sobre com i per a què usem les cookies. La Política de Cookies va actualitzar-se per darrera vegada a data del 11 de març de 2020.
Si tingués cap dubte, comentari o suggeriment sobre la Política de Cookies, pot escriure a la persona Delegada de Protecció de Dades: lopd@isglobal.org.
[Actualitzat el 11 de març de 2020 · Foto: Christopher Burns / Unsplash]

Segons la normativa de protecció de dades vigent, ISGlobal l’informa expressament del següent:
Quan se li sol·licitin dades personals per a la prestació de serveis, s’informarà l’usuari del caràcter necessari d’aquells que siguin considerats imprescindibles.
Si no es faciliten aquestes dades obligatòries, no serà possible la prestació dels serveis en qüestió. Les dades de caràcter personal que vostè faciliti o a les quals ISGlobal tingui accés com a conseqüència de la seva navegació, consulta i/o sol·licituds a través de la pàgina www.isglobal.org (el “Lloc Web”) s’incorporaran a un fitxer titularitat d’ISGlobal, amb la finalitat de gestionar, mantenir i controlar les seves sol·licituds d’informació i/o contractació dels béns i/o serveis oferts a través del Lloc Web. La informació que rep ISGlobal dels usuaris del lloc web a través de la subscripció a esdeveniments promocionals o de l’enviament de formularis es tracta amb la màxima confidencialitat, amb la finalitat d’atendre la seva participació a l’esdeveniment i d’enviar-li informació, en el segon cas. La informació rebuda no s’utilitza per a cap altra finalitat.
Les dades personals facilitades no es comunicaran ni es cediran a tercers sense consentiment previ de l’interessat.
Quan se sol·liciti omplir un formulari, s’informarà la persona usuària de la identitat i les dades del responsable del tractament de les dades i de la persona Delegada de Protecció de Dades, de les finalitats i de la base jurídica del tractament, dels destinataris de les dades i, en cas que calgui, de les transferències internacionals de les dades, dels terminis de conservació de les dades i de la facultat de l’usuari d’exercir els seus drets d’accés, rectificació, supressió, portabilitat, limitació i/o oposició al tractament, del dret a presentar una reclamació davant l’autoritat de control i de l’existència de decisions automatitzades. Les dades personals recollides només seran tractades i/o cedides amb la finalitat expressada i sempre amb el consentiment de l’usuari.
L’enviament d’informació mitjançant el/els formularis del lloc web sempre va precedit de la conformitat voluntària mitjançant la selecció d’un botó “ACCEPTAR/ENVIAR” (o similar), per la qual cosa ISGlobal disposa de la prova del consentiment de l’usuari al tractament de les seves dades personals.
La persona usuària respondrà, en qualsevol cas, del fet que les dades facilitades siguin veritables, exactes, completes i actualitzades, i ISGlobal es reservarà el dret d’excloure de la informació o dels serveis sol·licitats a qualsevol usuari que hagi facilitat dades falses, sense perjudici d’altres accions legalment procedents.
En virtut d’allò que es disposa a l’article 22 de la LSSI, ISGlobal podrà utilitzar dispositius d’emmagatzematge i recuperació de dades (“cookies”) en equips terminals dels destinataris, amb la condició que aquests hagin donat el seu consentiment un cop se’ls hagi facilitat informació clara i completa sobre la seva utilització. Els usuaris podran obtenir tota la informació sobre la finalitat de la instal·lació de les cookies i els usos que se’ls donarà a la Política de cookies d’ISGlobal.
Tot allò descrit anteriorment no impedirà el possible emmagatzematge o accés de tipus tècnic amb l’única finalitat d’efectuar la transmissió d’una comunicació per una xarxa de comunicaciones electròniques o, en la mesura que resulti estrictament necessari, per a la prestació d’un servei de la societat de la informació sol·licitat expressament pel destinatari.
La persona usuària podrà exercir els drets d’accés, rectificació, supressió, oposició, portabilitat i limitació del tractament mitjançant una sol·licitud dirigida a la persona Delegada de Protecció de Dades a través de l’adreça d’e-mail lopd@isglobal.org o per correu postal a l’adreça d’ISGlobal: c/ Rosselló, número 132, 7a planta, 08036 Barcelona. La sol·licitud haurà d’indicar el nom i cognoms de l’usuari, el domicili a efectes de notificacions, una fotocòpia del Document d’Identitat o passaport i la indicació del dret que s’exerceix.
Així mateix, si no està d’acord amb el tractament dut a terme per ISGlobal o considera que s’han vulnerat els seus drets, podrà presentar una reclamació en qualsevol moment a l’Agència Espanyola de Protecció de Dades (www.aepd.es – C/ Jorge Juan, 6, Madrid).
ISGlobal ha implantat les mesures de seguretat tècniques i organitzatives necessàries per garantir la seguretat de les seves dades de caràcter personal i evitar-ne l’alteració, pèrdua, tractament i/o accés no autoritzat, tenint en compte l'estat de la tecnologia, la naturalesa de les dades emmagatzemades i els riscos q què estan exposades, bé provinguin de l'acció humana com del medi físic o natural, tot això de conformitat amb el que es preveu en la normativa vigent.
De conformitat amb allò establert a la Llei 34/2002, d’11 de juliol, de Serveis de la Societat de la Informació i de Comerç Electrònic, en el supòsit que vostè no desitgi rebre comunicacions comercials electròniques en el futur, per part d’ISGlobal, podrà manifestar aquesta voluntat enviant un correu electrònic a la persona Delegada de Protecció de Dades (lopd@isglobal.org).
[Actualitzat el 11 de març de 2020 · Foto: Gilles Lambert / Unsplash]
Quan visiteu qualsevol lloc web, pot emmagatzemar o recuperar informació al vostre navegador, principalment en forma de galetes (cookies). Aquesta informació pot ser sobre vosaltres, les vostres preferències o el vostre dispositiu i s’utilitza principalment per fer que el lloc funcioni tal com espereu. La informació no sol identificar-vos directament, però us pot proporcionar una experiència web més personalitzada. Com que respectem el vostre dret a la privadesa, podeu optar per no permetre alguns tipus de cookies. Feu clic a les diferents categories per obtenir-ne més informació i canviar la configuració predeterminada. No obstant això, el bloqueig d'alguns tipus de cookies pot afectar la vostra experiència del lloc web i dels serveis que podem oferir.
Aquestes cookies són necessàries perquè el lloc web funcioni i no es poden desactivar als nostres sistemes. Normalment només s’estableixen en resposta a accions que feu, que suposen una sol·licitud de serveis, com ara establir les vostres preferències de privadesa, iniciar la sessió o omplir formularis. Podeu configurar el navegador per bloquejar-lo o alertar-lo sobre aquestes cookies, però algunes parts del lloc no funcionaran. Aquestes cookies no emmagatzemen cap informació d’identificació personal.
Detalls
| Cookie | Management | Duration | Aim |
|---|---|---|---|
| COOKIE_SUPPORT | First Party | 50 years | A cookie that checks whether cookies are enabled in your browser. |
| GUEST_LANGUAGE_ID | First Party | 50 years | Cookie used to remember the user's language preferences. |
| JSESSIONID | First Party | Session | Cookie used to manage web applications. |
| LFR_SESSION_STATE | First Party | Session | Liferay uses these cookies to manage your access ID |
| USER_UUID | First Party | Session | Liferay uses these cookies to manage your access ID |
| cp_sessionid | First Party | 5 years | |
| CK_CONSENT | First Party | 1 year | A cookie used to confirm the user's acceptance of first level cookies in response to the cookie warning. |
| COMPANY_ID | First Party | Session | Liferay company identifier |
| ID | First Party | Session | Liferay uses these cookies to manage your access ID |
| ck_fbanner | First Party | 14 days | A cookie used to check if the user already close footer banner. |
| ck_newsletter | First Party | 14 days | A cookie used to check if the user already close newsletter popup. |
| 1P_JAR | 1 month | These cookies are used to collect website statistics and track conversion rates. | |
| APISID | 2 years | Used by Google to store user preferences and information of Google | |
| HSID | 2 years | Used by Google to store user preferences and information of Google | |
| NID | 6 months | Advertising cookie used to tailor the advertisements shown to the interests of the user. | |
| S | Session | Used by Google to store user preferences and information of Google | |
| SAPISID | 2 years | Used by Google to store user preferences and information of Google | |
| SID | 2 years | Used by Google to store user preferences and information of Google | |
| SIDCC | 3 months | Used by Google to store user preferences and information of Google | |
| SSID | 2 years | Used by Google to store user preferences and information of Google | |
| __Secure-3PAPISID | 2 years | Used by for targeting purposes to build a profile of the website visitor's interests in order to show relevant & personalised Google advertising | |
| __Secure-3PSID | 2 years | Used by for targeting purposes to build a profile of the website visitor's interests in order to show relevant & personalised Google advertising | |
| __Secure-3PSIDCC | 2 years | Used by for targeting purposes to build a profile of the website visitor's interests in order to show relevant & personalised Google advertising | |
| CONSENT | 20 years | Used by Google to store user preferences and information of Google | |
| vuid | Vimeo | 2 years | A Vimeo Analytics cookie that provides a single id. |
| APISID | YouTube | 2 years | These cookies are set via embedded YouTube videos. They register anonymous statistical data |
| HSID | YouTube | 2 years | These cookies are set via embedded YouTube videos. They register anonymous statistical data |
| LOGIN_INFO | YouTube | 2 years | These cookies are set via embedded YouTube videos. They register anonymous statistical data |
| PREF | YouTube | 2 years | Cookie that remembers information that changes the appearance or behaviour of the web site, such as the user's preferred language or region. |
| SAPISID | YouTube | 2 years | These cookies are set via embedded YouTube videos. They register anonymous statistical data |
| SID | YouTube | 2 years | These cookies are set via embedded YouTube videos. They register anonymous statistical data |
| SIDCC | YouTube | 1 year | Used as security measure to protect users data from unauthorised access |
| SSID | YouTube | 2 years | These cookies are set via embedded YouTube videos. They register anonymous statistical data |
| VISITOR_INFO1_LIVE | YouTube | 1 year | A cookie that YouTube sets that measures your bandwidth to determine whether you get the new player interface or the old. |
| YSC | YouTube | Session | This cookie is set by the YouTube video service on pages with embedded YouTube video |
| CONSENT | YouTube | 20 years | Used by Google to store user preferences and information of Google |
| __Secure-3PAPISID | YouTube | 2 years | Used by for targeting purposes to build a profile of the website visitor's interests in order to show relevant & personalised Google advertising |
| __Secure-3PSID | YouTube | 2 years | Used by for targeting purposes to build a profile of the website visitor's interests in order to show relevant & personalised Google advertising |
| __Secure-3PSIDCC | YouTube | 2 years | Used by for targeting purposes to build a profile of the website visitor's interests in order to show relevant & personalised Google advertising |
| iutk | issuu | 10 years | Recognises the user's device and what Issuu documents have been read. |
| _initial_referrer | infogram | Session | Tells Infogram which site is embedding the content |
| ig_putma | infogram | Session | Session cookie |
Aquestes cookies ens permeten comptar visites i fonts de trànsit, la qual cosa ens permet mesurar i millorar el rendiment del nostre lloc web. Ens ajuden a conèixer quines pàgines són les més populars i quines les menys, com es mouen els visitants pel lloc web. Tota la informació que recullen aquestes cookies és agregada i, per tant, anònima. Si no permeteu aquestes cookies, no sabrem quan hàgiu visitat el nostre lloc i no podrem controlar-ne el rendiment.
Detalls
| Cookie | Management | Duration | Aim |
|---|---|---|---|
| _ga | Google Analytics | 2 years | This cookie is used to distinguishes unique users by assigning a randomly generated number as a client identifier. It is included in each page request in a site and used to calculate visitor, session and campaign data for the sites analytics reports. |
| _gat | Google Analytics | 1 minute | Used to throttle the request rate – limiting the collection of data on high traffic sites. |
| _gid | Google Analytics | 24 hours | Used to distinguish users |
Algunes d’aquestes cookies estan configurades per una sèrie de serveis de xarxes socials que hem afegit al lloc perquè pugueu compartir el nostre contingut amb els vostres amics i xarxes. Poden fer un seguiment del vostre navegador en altres llocs i crear un perfil dels vostres interessos. Això pot afectar el contingut i els missatges que veieu en altres llocs web que visiteu. Si no permeteu aquestes cookies, és possible que no pugueu utilitzar ni veure aquestes eines per compartir.
Algunes altres d'aquestes cookies poden ser establertes a través del nostre lloc per entitats publicitàries. Aquestes empreses les poden utilitzar per crear un perfil dels vostres interessos i mostrar-vos anuncis rellevants en altres llocs. No emmagatzemen directament informació personal, sinó que es basen en identificar de manera única el navegador i el dispositiu d’Internet. Si no permeteu aquestes cookies, experimentareu una publicitat menys orientada.
Detalls
| Cookie | Management | Duration | Aim |
|---|---|---|---|
| _gcl_au | 3 months | Used by Google for experimenting with advertisement efficiency | |
| IDE | Google (doubleclick) | 13 months | Used by Google to show relevant advertising to the viewer across the web |
| datr | 2 years | This cookie is used by facebook for security, to stop DDOS/fake accounts and to protect users content | |
| sb | 2 years | Allow you to control the “Follow us on Facebook” and “Like” buttons, collect the language settings and allow you to share the page. | |
| _fbp | 3 months | Store and track visits across websites. | |
| auth_token | 10 years | Track visitor activity from Twitter ads on our website, and also allow users to share content from our websites. They cookies do not provide us with any confidential information relating to your account. | |
| dnt | 10 years | These cookies enable users, if they wish, to login to their Twitter account share content from our websites with their friends. These cookies do not allow us access to your accounts or provide us with any confidential information relating to your accounts. | |
| twid | 10 years | Track visitor activity from Twitter ads on our website, and also allow users to share content from our websites. They cookies do not provide us with any confidential information relating to your account. | |
| wide | YouTube | Session | These cookies are set via embedded YouTube videos. They register anonymous statistical data |
| s_gl | YouTube | Session |